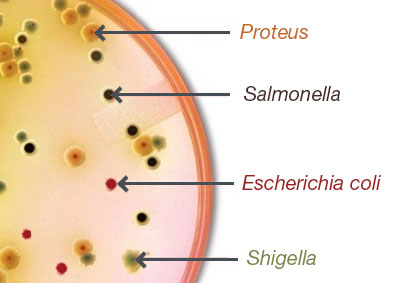

Herramientas de usuario
es:topicos:ident:bacteria:ass_colores_coliniasecolisalmoshig.jpg
ass_colores_coliniasecolisalmoshig.jpg

- Fecha:
- 2020/05/14 10:21
- Nombre del archivo:
- ass_colores_coliniasecolisalmoshig.jpg
- Formato:
- JPEG
- Tamaño:
- 21KB
- Ancho:
- 400
- Alto:
- 283
- Referencias para:
- solucion_nutritiva
Puede que esta lista no esté completa debido a restricciones de la ACL y a las páginas ocultas.